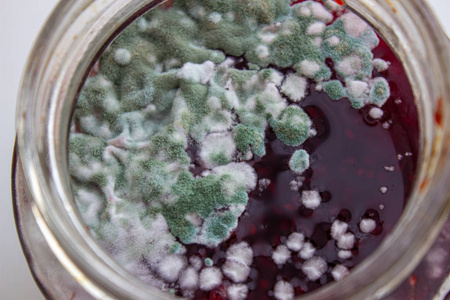
发霉产品图片
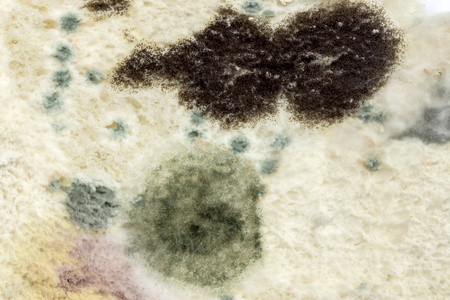
霉菌丝图片

白霉菌

同时模具特写,土壤上的白霉菌特写
图片尺寸1023x681
白色链霉菌
图片尺寸268x200
盆土表面有白色霉菌教你几种方法清除都不用买杀菌剂
图片尺寸1024x683
发霉产品图片
图片尺寸450x300
呵呵发霉的白墙广东的回南天
图片尺寸1080x1439
细菌霉菌图片
图片尺寸450x300
房子的白墙上有霉菌
图片尺寸1200x884
桃子上的"白头发"—孩子眼中的为什么?(六)
图片尺寸800x776
霉菌丝图片
图片尺寸450x300
发霉的图片
图片尺寸850x1024
白霉菌对人体有害,屋里霉菌对人体有哪些危害图2
图片尺寸600x363
白墙上的霉菌作为背景
图片尺寸987x1200
从室内空气中培养的霉菌菌落
图片尺寸1200x800
发霉的白面包
图片尺寸1200x800
它的毒性比砒霜大68倍,仅次于肉毒霉素,是目前已知霉菌中毒性最强的.
图片尺寸400x300
培养皿与模具,与白霉菌培养皿
图片尺寸1023x682
全发白霉菌
图片尺寸4032x3024
白霉菌对人体有害,屋里霉菌对人体有哪些危害图3
图片尺寸600x361
葡萄叶背有白色霉层,是什么病,怎么防治?(如图)
图片尺寸712x960
组里面收的闲置,今天打开一看好多白点点,这是发霉了吗
图片尺寸1080x810